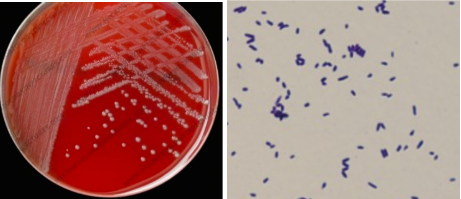
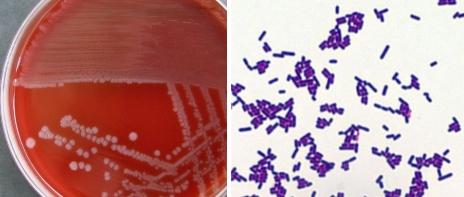
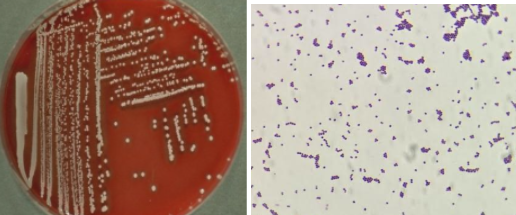
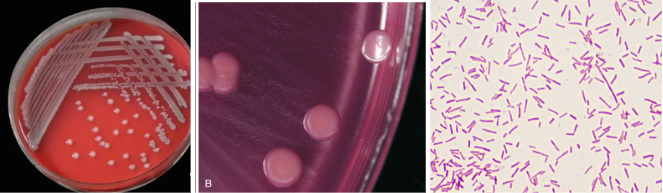
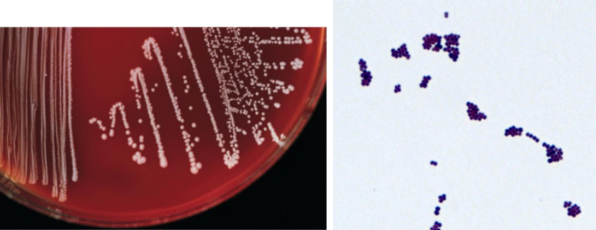
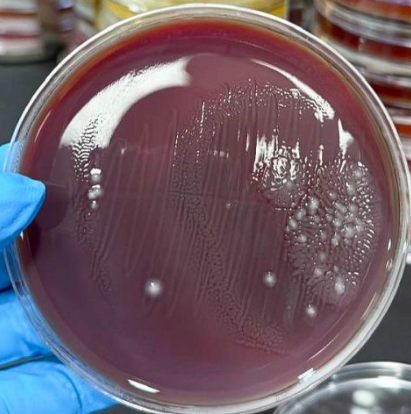
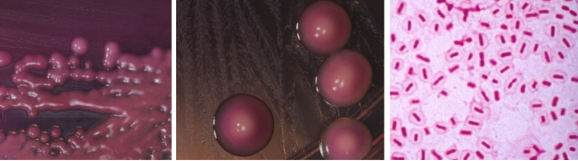
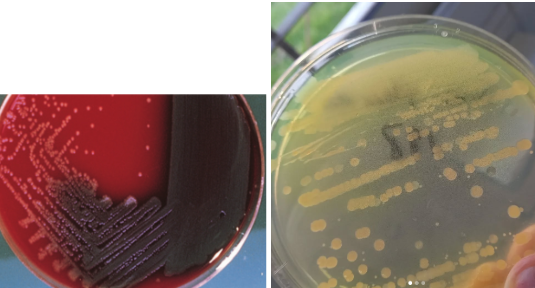
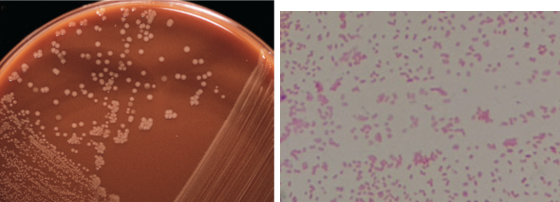
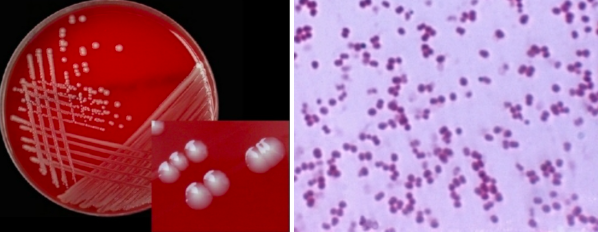
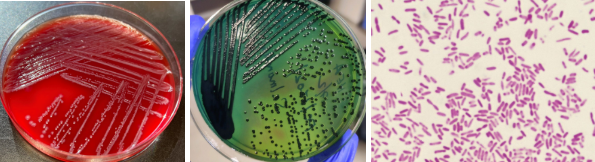
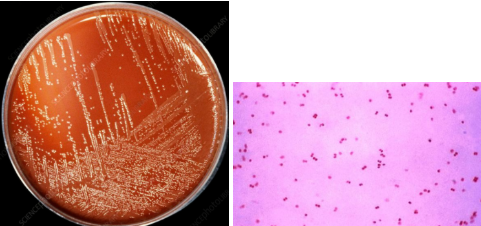
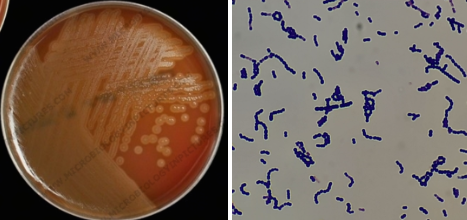
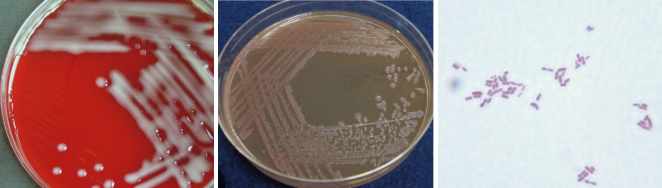
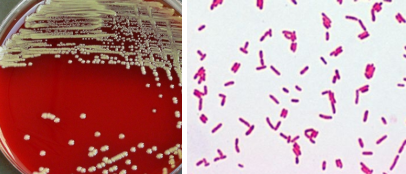
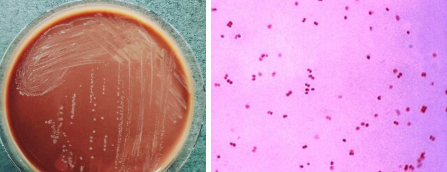
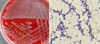

Blood Culture from 72 yr old male (immunocompromised)
Catalase: Positive
What is the Colony Morphology on BAP?
1. provide gram stain from the primary culture at 24hrs:
2. List tests required to identify this isolate, include the expected reaction.
3. What organism do you suspect?
Colony Morphology: 4+, small, white, NH, dry, domed
1) small GPR palisade
2) Vitek GP-ID
3) Corynebacterium sp.
Blood Culture from 5-day old female)
Catalase: Positive
What is the Colony Morphology on BAP?
1. provide gram stain from the primary culture at 24hrs:
2. List tests required to identify this isolate, include the expected reaction.
3. What organism do you suspect?
4. write a preliminary report to the clinician based on what you know at this point
Colony Morphology: 4+, small, grey, Beta hem
1) small GPR
2) Vitek
3) Listeria monocytogenes
4) 4+ GPR Isolated, IP, FRTF
Blood Culture from 65yr old male hospitalized
Catalase: Positive
Bactistaph: positive
What is the Colony Morphology on BAP?
1. provide gram stain from the primary culture at 24hrs:
2. List tests required to identify this isolate, include the expected reaction.
3. What organism do you suspect?
4. write a preliminary report to the clinician based on what you know at this point
Colony Morphology: 4 + yellow-white, Beta hem or NH, medium, buttery
1) GPC in clusters
2) Vitek GP ID
3) Staphylococcus aureus
4) 4+ staphylococcus aureus identified, SIP, FRTF
Decubitus ulcer wound
Indole odor
What is the Colony Morphology on BAP?
1. provide gram stain from the primary culture at 24hrs:
2. List tests required to identify this isolate, include the expected reaction.
3. What organism do you suspect?
4. write a preliminary report to the clinician based on what you know at this point

Colony Morphology: 4+, grey, large, Beta hem, indole odor
1) GNR
2) Oxidase: NALF, Indole: positive
3) Escherichia Coli
4) Escherichia Coli, ID, SIP; FRTF
Abdominal wound
Indole Positive
What is the Colony Morphology on BAP?
1. provide gram stain from the primary culture at 24hrs:
2. List tests required to identify this isolate, include the expected reaction.
3. What organism do you suspect?
4. write a preliminary report to the clinician based on what you know at this point
Colony Morphology: 4+, grey, large, Beta hem, indole odor
1) GNR
2) Oxidase: NALF, Indole: positive
3) Escherichia Coli
4) Escherichia Coli, ID, SIP; FRTF
Decubitus ulcer wound
NLF
What is the Colony Morphology on BAP?
1. provide gram stain from the primary culture at 24hrs:
2. List tests required to identify this isolate, include the expected reaction.
3. What organism do you suspect?
4. write a preliminary report to the clinician based on what you know at this point
Colony Morphology: 4+, small, white, NH
1) GPC in clusters
2) Catalase: positive, Bactistaph: Negative
3) Coagulase Negative Staphylococcus aureus
4) Coagulase Negative Staphylococcus aureus, ID, SIP; FRTF
Abdominal wound
Oxidase Negative
What is the Colony Morphology on BAP?
1. provide gram stain from the primary culture at 24hrs:
2. List tests required to identify this isolate, include the expected reaction.
3. What organism do you suspect?
4. write a preliminary report to the clinician based on what you know at this point
Colony Morphology: 4+, large, grey, NH
1) GNR
2) Vitek GN-ID
3) Any NLF Enteric (other growth present)
4) 4+, GNR, identified, SIP, FRTF
Sputum Culture 58 yr old male, outpatient
What is the Colony Morphology on BAP?
1. Is there a pathogen present? (yes/no)
2. What organism do you suspect?
3. write a preliminary report to the clinician based on what you know at this point

Colony Morphology: NRF
1) No
2) NRF
3) 4+ NRF
Sputum Culture 58 yr old female, outpatient
What is the Colony Morphology on BAP?
1. Is there a pathogen present? (yes/no)
2. List tests required to identify this isolate, include the expected reaction.
3. What organism do you suspect?
4. write a preliminary report to the clinician based on what you know at this point

Colony Morphology: 4+, small, grey, alpha hem, umbilicate, translucent
1) Yes
2) catalase: Negative, Bile Solubility: Positive
3) Streptococcus pneumoniae
4) 4+ streptococcus pneumoniae identified, SIP, FRTF
Sputum Culture 67 yr old female, outpatient
What is the Colony Morphology on BAP?
1. Is there a pathogen present? (yes/no)
2. List tests required to identify this isolate, include the expected reaction.
3. What organism do you suspect?
4. write a preliminary report to the clinician based on what you know at this point
Colony Morphology: 3+, large, grey, NH, mucoid
1) Yes
2) Oxidase:NALF, VitekGN-ID
3) Klebsiella Pneumoniae
4) 3+ Klebsiella pneumoniae identified, SIP, FRTF
Sputum Culture Cystic Fibrosis- hospitalized
What is the Colony Morphology on BAP?
1. Is there a pathogen present? (yes/no)
2. List tests required to identify this isolate, include the expected reaction.
3. What organism do you suspect?
4. write a preliminary report to the clinician based on what you know at this point
Colony Morphology: 4+, large, metallic sheen, Beta hem, corn tortilla odor, irregular
1) Yes
2) Oxidase: positive, VitekGN-ID
3) Pseudomonas aeruginosa
4) 4+ Pseudomonas aeruginosa identified, SIP, FRTF
Sputum Culture 64 yr old male
What is the Colony Morphology on CHOC?
1. Is there a pathogen present? (yes/no)
2. List tests required to identify this isolate, include the expected reaction.
3. What organism do you suspect?
4. write a preliminary report to the clinician based on what you know at this point
Colony Morphology: 4+, small, grey, translucent, wet mouse smell
1) Yes
2) Oxidase: weak positive, NH Panel Haemophilus
3) Haemophilus influenzae
4) 4+ Haemophilus Influenzae identified, SIP, FRTF
Sinus exudate 48 yr old female, outpatient
What is the Colony Morphology on BAP?
1. Provide a gram stain report from the primary culture at 24 hrs:
2. List tests required to identify this isolate, include the expected reaction.
3. What organism do you suspect?
4. write a preliminary report to the clinician based on what you know at this point
Colony Morphology: 3+, medium, white, pushy, dry
1) GNDC Kidney bean
2) Oxidase: positive, Catarrhalis Disk test: positive
3) Moraxella catarrhalis
4) 3+ Moraxella catarrhalis identified, SIP, FRTF
Peritoneal Abscess
What is the Colony Morphology on BAP?
1. Provide a gram stain report from the primary culture at 24 hrs:
2. List tests required to identify this isolate, include the expected reaction.
3. What organism do you suspect?
4. write a preliminary report to the clinician based on what you know at this point

Colony Morphology: Grey swarming
1) GNR
2) Indole: negative
3) Proteus Mirabilis
4) 4+ Proteus Mirabilis identified, SIP, FRTF
Peritoneal Abscess
What is the Colony Morphology on BAP?
1. Provide a gram stain report from the primary culture at 24 hrs:
2. List tests required to identify this isolate, include the expected reaction.
3. What organism do you suspect?
4. write a preliminary report to the clinician based on what you know at this point

Colony Morphology: Grey, small, beta hem
1) GPC in chains
2) catalase: negative, PYR: Positive
3) Streptococcus pyogenes
4) 4+ Streptococcus pyogenes identified, SIP, FRTF
Stool
What is the Colony Morphology on BAP?
1. Is there a pathogen present? (yes/no)
2. List tests required to identify this isolate, include the expected reaction.
3. What organism do you suspect?
4. write a preliminary report to the clinician based on what you know at this point

Colony Morphology: 4+, large, grey, Beta hem, indole odor
1) No
2) NALF
3) Escherichia Coli
4) 4+ Escherichia Coli identified, SIP, FRTF
Stool
What is the Colony Morphology on BAP?
1. Is there a pathogen present? (yes/no)
2. List tests required to identify this isolate, include the expected reaction.
3. What organism do you suspect?
4. write a preliminary report to the clinician based on what you know at this point
Colony Morphology: 4+, large, yellow-grey, NH
1) yes
2) Oxidase: Negative, VitekGN-ID
3) Shigella Sp.
4) 4+ Probable Shigella Sp. isolated, IP, No NFF
Stool
What is the Colony Morphology on BAP?
1. Is there a pathogen present? (yes/no)
2. List tests required to identify this isolate, include the expected reaction.
3. What organism do you suspect?
4. write a preliminary report to the clinician based on what you know at this point

Colony Morphology: 4+, large, grey, NH
1) yes
2) Oxidase: Negative, VitekGN-ID
3) Salmonella Sp.
4) 4+ Probable Salmonella Sp. isolated, IP, No NFF
Blood culture from 12 yr old male
What is the Colony Morphology on BAP?
1. Provide a gram stain report from the primary culture at 24 hrs:
2. List tests required to identify this isolate, include the expected reaction.
3. What organism do you suspect?
4. write a preliminary report to the clinician based on what you know at this point
Colony Morphology: Small, grey, shiny, NH
1) GNDC Kidney bean
2) Oxidase: Positive, NH panel Neisseria
3) Neisseria Meningitidis
3) 4+ Neisseria Meningitidis identified, SIP, FRTF
31 yr old male patient with endocarditis
What is the Colony Morphology on BAP?
1. Provide a gram stain report from the primary culture at 24 hrs:
2. List tests required to identify this isolate, include the expected reaction.
3. What organism do you suspect?
4. write a preliminary report to the clinician based on what you know at this point
Colony Morphology: Small, grey, shiny, NH
1) GPC in chains
2) Catalase: Negative, VitekGP-ID
3) Streptococcus viridans
3) 4+ Streptococcus viridans identified, SIP, FRTF
sputum swab in 7 day old female
What is the Colony Morphology on BAP?
1. Provide a gram stain report from the primary culture at 24 hrs:
2. List tests required to identify this isolate, include the expected reaction.
3. What organism do you suspect?
4. write a preliminary report to the clinician based on what you know at this point

Colony Morphology: medium, grey, beta hem
1) GPC in chains
2) Catalase: Negative, Pathodex for B bead
3) Streptococcus agalactiae
3) 4+ Streptococcus agalactiae identified, SIP, FRTF
Burn patient
What is the Colony Morphology on BAP?
1. Provide a gram stain report from the primary culture at 24 hrs:
2. List tests required to identify this isolate, include the expected reaction.
3. What organism do you suspect?
4. write a preliminary report to the clinician based on what you know at this point
Colony Morphology: mauve, stringy, mucoid, NH
1) GNR
2) Oxidase: Negative, VitekGN-ID
3) Acinetobacter
3) 4+ Acinetobacter identified, SIP, FRTF
** wound of 34 yr old male rehab patient **
What is the Colony Morphology on BAP?
1. Provide a gram stain report from the primary culture at 24 hrs:
2. List tests required to identify this isolate, include the expected reaction.
3. What organism do you suspect?
4. write a preliminary report to the clinician based on what you know at this point
Colony Morphology: tan, small, wrinkled, NH
1) GNR
2) Oxidase: Negative, VitekGN-ID
3) Burkholderia cepacia
3) 4+ Burkholderia cepacia identified, SIP, FRTF
23 yr old female, outpatient
What is the Colony Morphology on BAP?
1. Provide a gram stain report from the primary culture at 24 hrs:
2. List tests required to identify this isolate, include the expected reaction.
3. What organism do you suspect?
4. write a preliminary report to the clinician based on what you know at this point
Colony Morphology: tan-grey, small, raised, NH
1) GNDC kidney bean
2) Oxidase: Positive, NH Panel Neisseria
3) Neisseria gonorrhoeae
3) 4+ Neisseria gonorrhoeae identified, SIP, FRTF